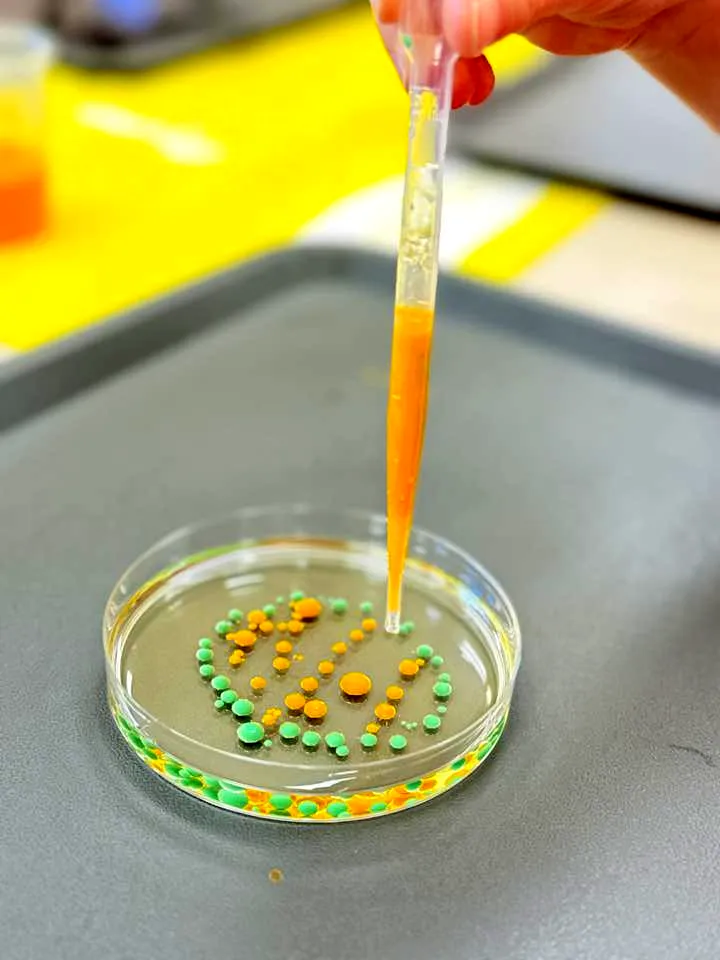

Tworzymy miejsce, gdzie każde dziecko jest traktowane indywidualnie, a każda aktywność to coś więcej niż animacja – to przemyślany element wspierający rozwój, emocje i radość.
Miśkolandia – Centrum Edukacji i Animacji
Witaj w Miśkolandii – miejscu, gdzie każda zabawa ma sens, a każde dziecko znajduje przestrzeń do odkrywania siebie.
Nasze zajęcia sensoryczne, kreatywne warsztaty i wyjątkowe urodziny tworzymy z pasją, sercem i odrobiną magii.
Bo w Miśkolandii wierzymy, że dzieci zasługują na coś więcej niż tylko “czas wolny” – one zasługują na wspomnienia.
Rodzice nam ufają
bo Miśkolandia to coś więcej niż zabawa
Dlaczego rodzice wybierają właśnie nas?
💙 Bezpieczeństwo i empatia – dzieci są pod opieką zaangażowanego, doświadczonego zespołu
💙 Indywidualne podejście – dopasowujemy warsztaty i animacje do potrzeb dzieci i rodziców
💙 Pasja i energia – każda zabawa płynie z autentycznego zaangażowania
💙 Wysoka jakość zajęć – autorskie programy, kreatywne formy i starannie dobrane materiały
💙 Pozytywne opinie – rodzice polecają nas dalej, a dzieci nie chcą wychodzić 🙂
”„Animacje z panią Miśką to super przygoda i moc zabaw dla dzieci w każdym wieku 🤓”
Michał Kowalczykopinia z Facebook
O Miśkolandii
z serca do dzieci
Miśkolandia to miejsce stworzone z pasji i potrzeby dawania dzieciom przestrzeni do zabawy, rozwoju i tworzenia wspomnień.
Nie mamy gotowych szablonów – tworzymy autentyczne scenariusze animacji, urodzin, warsztatów i wydarzeń specjalnych, które rozweselają, uczą i zostają w pamięci na długo.
To, co robimy, wynika z potrzeby serca – a nie z tabelki Excel. I chyba właśnie dlatego to działa.
Co nas wyróżnia?
🧸 Autorskie programy zajęć i animacji
🧸 Doświadczony i twórczy zespół
🧸 Elastyczność i mobilność – pracujemy też w placówkach
🧸 Pełne zaangażowanie – każde wydarzenie jest „nasze”
🧸 Kolor, radość i wartości – to wszystko u nas gra razem
Nasza oferta
Zajęcia i animacje, które rozwijają, bawią i tworzą niezapomniane wspomnienia
W Miśkolandii tworzymy przestrzeń, gdzie każde dziecko może odkrywać świat poprzez zabawę, rozwijać swoje umiejętności i budować relacje. Nasza oferta to połączenie pasji, doświadczenia i kreatywności, dostosowane do indywidualnych potrzeb każdego malucha.
Co mówią o nas rodzice?
Nic nie cieszy nas bardziej niż uśmiech dziecka i wiadomość od zadowolonego rodzica. Oto kilka słów od osób, które nam zaufały.
Aktualny harmonogram zajęć
Sprawdź, kiedy odbywają się nasze warsztaty, zajęcia sensoryczne i urodzinki.
Jeśli chcesz zapisać swoje dziecko – skontaktuj się z nami wcześniej, miejsca są ograniczone!
Dzień 🗓
Godzina 🕓
Zajęcia 🧩
📍 Miejsce
Poniedziałek
17:00
SensoRaczki
Wtorek
10:0015:0017:00
SensoRaczki
Środa
8:00 – 13:0017:00 – 19:00
Mobilne zajęcia
Urodzinki
Miśkolandia – Osieczna
Czwartek
8:00 – 13:0017:00 – 19:00
Mobilne zajęcia
Urodzinki
Miśkolandia – Osieczna
Piątek
8:00 – 13:0017:00 – 19:00
Mobilne zajęcia
Urodzinki
Miśkolandia – Osieczna
Sobota
10:00 – 12:0013:00 – 15:0016:00 – 18:00
Urodzinki
Dzień | Godzina
Zajęcia | Miejsce
Wiedza, która pomaga – blog i aktualności
Rodzice chętnie czytają porady dotyczące wychowania, edukacji i adaptacji dziecka w przedszkolu. Strona Twojej placówki może stać się miejscem, które nie tylko informuje, ale także edukuje i buduje zaangażowanie rodziców.
📌 Przykładowe tematy artykułów:
To może być Twoja strona
To może być Twoja strona
To może być Twoja strona
To może być Twoja strona
To może być Twoja strona
To może być Twoja strona
Miśkolandia w akcji! 📸
Zobacz, jak wygląda radość na twarzach dzieci. Tak właśnie bawimy się i uczymy – przez zabawę, emocje i wyjątkowe chwile.
Rekrutacja – Jak szybko uruchomić nowoczesną stronę dla Twojej placówki?
Proces rekrutacji do przedszkola lub żłobka może być szybki i bezproblemowy! Dzięki intuicyjnej stronie internetowej rodzice będą mogli łatwo znaleźć formularz zgłoszeniowy i poznać wszystkie szczegóły dotyczące zapisów.
1️⃣ Skontaktuj się z nami – poznaj rozwiązania dla Twojej placówki 📞💬
Czy Twoja placówka jest gotowa na nowoczesną stronę, która zwiększy liczbę zapisów? Skontaktuj się z nami, aby omówić szczegóły i sprawdzić, jak możemy pomóc!
📞 Telefon: 608 057 499
📧 E-mail: kontakt@miskolandia.pl
💡 Rodzice odwiedzający stronę muszą szybko znaleźć odpowiednie informacje – my zadbamy o to, aby wszystko było przejrzyste i intuicyjne!
2️⃣ Umów się na prezentację online lub wdrożenie strony 🏡👩🏫
Czy chcesz zobaczyć, jak może wyglądać Twoja nowa strona w praktyce? Zapraszamy na konsultację online, podczas której zaprezentujemy gotowe rozwiązanie i omówimy szczegóły dostosowane do Twojej placówki.
📍 Wersja demonstracyjna dostępna od ręki – zobacz, jak działa na realnych przykładach!
📅 Zarezerwuj dogodny termin na prezentację lub rozpocznij wdrożenie – Twoja strona będzie gotowa w 48h!
3️⃣ Wypełnij formularz i uruchom stronę 📄✍️
Decyzja podjęta? Świetnie! Teraz czas na uruchomienie Twojej strony – szybki i prosty proces, który nie zajmie Ci więcej niż 30 minut.
✔ Wypełnij formularz zgłoszeniowy – dostosujemy treści do Twojej placówki
✔ Prześlij nam swoje logo, zdjęcia i dane kontaktowe – my zajmiemy się resztą
✔ Dokonaj płatności – strona zostanie uruchomiona w ciągu 48 godzin!
💰 Cennik wdrożenia:
🔹 Wersja pełna – 5200 zł jednorazowo lub 540 zł/mies.
🔹 Wersja prostsza – 2900 zł jednorazowo lub 300 zł/mies.
📌 Możliwość płatności ratalnej – elastyczne rozwiązanie bez dużego wydatku jednorazowego!
4️⃣ Adaptacja – szybki i sprawny start Twojej nowej strony 👶❤️
Wiemy, że wdrożenie nowej strony może budzić wątpliwości – dlatego działamy tak, aby było to jak najprostsze!
✔ Indywidualne dostosowanie treści – pomożemy Ci stworzyć idealną stronę
✔ Przejrzysta struktura – Twoi klienci (rodzice) łatwo znajdą wszystkie informacje
✔ Szybka realizacja – gotowa strona w 48h!
💡 Chcesz dowiedzieć się więcej? Przeczytaj nasz poradnik: „Jak nowoczesna strona zwiększa liczbę zapisów do przedszkola?”
Skontaktuj się z nami
Masz pytania dotyczące zajęć, urodzin lub warsztatów?
Chcesz dowiedzieć się, czy mamy wolne terminy?
📞 Zadzwoń: 666 156 268
✉️ Napisz: misko_landia@wp.pl
📍 Przyjedź: Osieczna, ul. Kościuszki 36a
Wolisz napisać przez formularz?